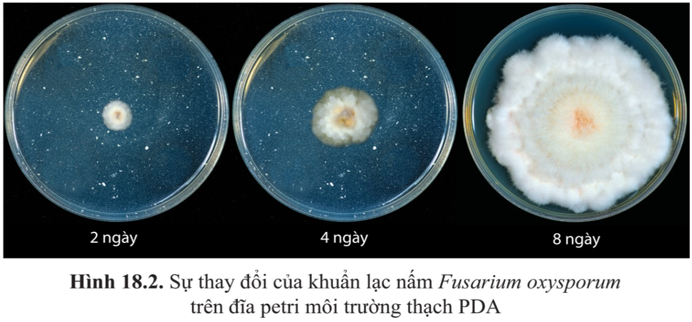
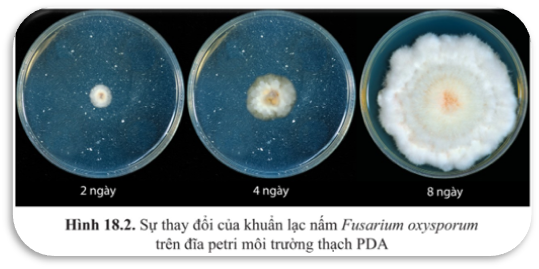

Thông báo


Đồng ý
Đồng ý
Thông báo

Nhóm câu hỏi:
Tổng số câu:
Số câu đúng:
Số điểm / Tổng điểm:
Tỷ lệ % đúng:
| STT | Tên câu hỏi | Loại câu | Kết quả | Xem lại |
Đồng ý

Thông báo

Nhóm câu hỏi:
Tổng số câu:
Số câu đúng:
Số điểm / Tổng điểm:
Tỷ lệ % đúng:
Đỗ roài
Xem lại
Tiếp tục

| STT | Tên câu hỏi | Loại câu | Kết quả | Xem lại |
SINH TRƯỞNG VÀ SINH SẢN Ở VI SINH VẬT(T1)

| Giáo viên: |
| MAI NỮ ANH PHÚC |
| Môn học: |
| SINH HỌC |
DÀN BÀI
XEM TRƯỚC
TRANG BÌA
00:15
TÊN BÀI
00:19
MỤC TIÊU BÀI HỌC
00:42
NỘI DUNG BÀI HỌC
00:20
KHỞI ĐỘNG
00:23
1.SINH TRƯỞNG CỦA VI SINH VẬT
00:58
VÍ DỤ, NHẬN XÉT, GIẢI THÍCH
00:43
KN SINH TRƯỞNG VSV
00:10
NỘI DUNG KHÁI NIỆM
00:15
PHIM SINH TRƯỞNG VSV
00:58
2.CÁC PHA ST CỦA QT VSV
00:43
HÌNH ẢNH MÔ TẢ
00:54
NỘI DUNG 4 PHA SINH TRƯỞNG
01:54
CÂU HỎI THU NHẬN SINH KHỐI
00:33
LUYỆN TẬP-VẬN DUNG
00:13
CÂU HỎI TT HS
01:25
HƯỚNG DẪN VỀ NHÀ
00:27
KẾT THÚC
00:13
TRANG BÌA
00:15
TÊN BÀI
00:19
MỤC TIÊU BÀI HỌC
00:42
NỘI DUNG BÀI HỌC
00:20
KHỞI ĐỘNG
00:23
1.SINH TRƯỞNG CỦA VI SINH VẬT
00:58
VÍ DỤ, NHẬN XÉT, GIẢI THÍCH
00:43
KN SINH TRƯỞNG VSV
00:10
NỘI DUNG KHÁI NIỆM
00:15
PHIM SINH TRƯỞNG VSV
00:58
2.CÁC PHA ST CỦA QT VSV
00:43
HÌNH ẢNH MÔ TẢ
00:54
NỘI DUNG 4 PHA SINH TRƯỞNG
01:54
CÂU HỎI THU NHẬN SINH KHỐI
00:33
LUYỆN TẬP-VẬN DUNG
00:13
CÂU HỎI TT HS
01:25
HƯỚNG DẪN VỀ NHÀ
00:27
KẾT THÚC
00:13